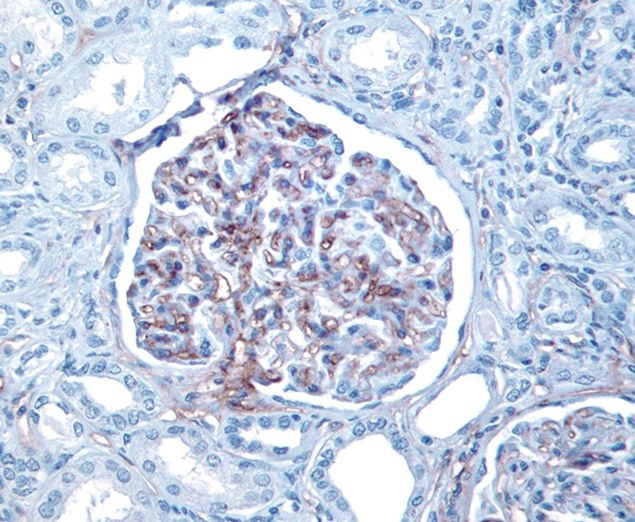
CD34 Antibody in Immunohistochemistry (IHC)

Search
Invitrogen
CD34 Monoclonal Antibody (BI-3C5)
{{$productOrderCtrl.translations['antibody.pdp.commerceCard.promotion.promotions']}}
{{$productOrderCtrl.translations['antibody.pdp.commerceCard.promotion.viewpromo']}}
{{$productOrderCtrl.translations['antibody.pdp.commerceCard.promotion.promocode']}}: {{promo.promoCode}} {{promo.promoTitle}} {{promo.promoDescription}}. {{$productOrderCtrl.translations['antibody.pdp.commerceCard.promotion.learnmore']}}






Please note: We are reviewing Western blot images included in the antibody testing data in our catalog, including those provided by third parties. Unless expressly labeled or annotated as “raw-unedited”, Western blot images included in the antibody testing data in our catalog may have been edited, optimized or otherwise adjusted for presentation.
产品信息
07-3403
种属反应
已发表种属
宿主/亚型
分类
类型
克隆号
抗原
偶联物
形式
浓度
规格
纯化类型
保存液
内含物
保存条件
运输条件
RRID
靶标信息
CD34 is a highly glycosylated monomeric with a molecular weight range of 111-115 kDa surface protein that is present on many stem cell populations. CD34 is a stem cell marker although its expression on human hematopoietic stem cells is reversible. CD34 may serve as a surface receptor that undergoes receptor-mediated endocytosis and regulates adhesion, differentiation and proliferation of hematopoietic stem cells and other progenitors. CD34 expression is likely to represent a specific state of hematopoietic development that may have altered adhering properties with expanding and differentiating capabilities in both in vitro and in vivo conditions. CD34 is possibly an adhesion molecule with a putative role for mediating the attachment of stem cells to the bone marrow extracellular matrix or directly to stromal cells. Further, CD34 could act as a scaffold for the attachment of lineage specific glycans, allowing stem cells to bind to lectins expressed by stromal cells or other marrow components. CD34 is thought to have a role in presenting carbohydrate ligands to selectins. The intracellular chain of the CD34 antigen is a site of phosphorylation by activated protein kinase C suggesting a putative role in signal transduction. Diseases associated with CD34 dysfunction include dermatofibrosarcoma and neurofibroma.
仅用于科研。不用于诊断过程。未经明确授权不得转售。
生物信息学
蛋白别名: Mucosialin; RP11-328D5.2